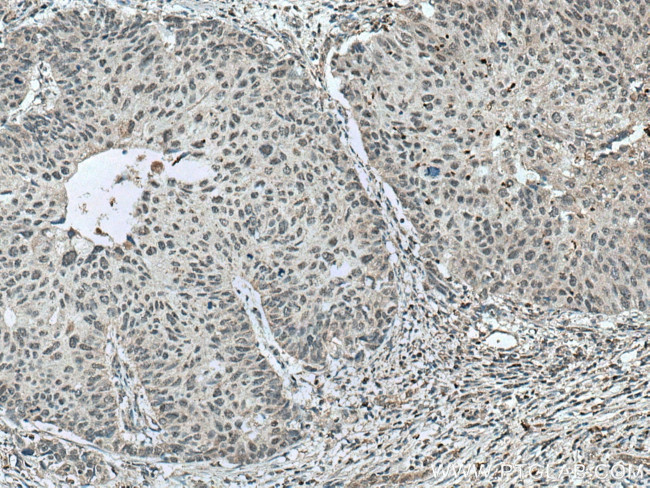
NR1H4 Antibody in Immunohistochemistry (Paraffin) (IHC (P))

Search
Proteintech
NR1H4 Polyclonal Antibody
{{$productOrderCtrl.translations['antibody.pdp.commerceCard.promotion.promotions']}}
{{$productOrderCtrl.translations['antibody.pdp.commerceCard.promotion.viewpromo']}}
{{$productOrderCtrl.translations['antibody.pdp.commerceCard.promotion.promocode']}}: {{promo.promoCode}} {{promo.promoTitle}} {{promo.promoDescription}}. {{$productOrderCtrl.translations['antibody.pdp.commerceCard.promotion.learnmore']}}
产品信息
25055-1-AP
种属反应
已发表种属
宿主/亚型
分类
类型
抗原
偶联物
形式
浓度
规格
纯化类型
保存液
内含物
保存条件
运输条件
产品详细信息
Immunogen sequence: MGSKMNLIE HSHLPTTDEF SFSENLFGVL TEQVAGPLGQ NLEVEPYSQY SNVQFPQVQP QISSSSYYSN LGFYPQQPEE WYSPGIYELR RMPAETLYQG ETEVAEMPVT KKPRMGASAG RI (1-121 aa encoded by BC130573)
靶标信息
FXR (farnesoid X receptor; NR1H4) belongs to nuclear receptor superfamily of ligand-activated transcription factors (NR1 subfamily) and acts as a receptor for bile acids such as chenodeoxycholic acid, lithocholic acid and deoxycholic acid. FXR plays an essential role in bile acid homeostasis through the regulation of genes involved in bile acid synthesis, conjugation and enterohepatic circulation. FXR also regulates lipid and glucose homeostasis and is involved innate immune response. The FXR-RXR heterodimer binds predominantly to farnesoid X receptor response elements (FXREs) containing two inverted repeats of the consensus sequence 5'-AGGTCA-3' in which the monomers are spaced by 1 nucleotide (IR-1) but also to tandem repeat DR1 sites with lower affinity, and can be activated by either FXR or RXR-specific ligands. In the liver FXR activates transcription of the corepressor NR0B2 thereby indirectly inhibiting CYP7A1 and CYP8B1 (involved in BA synthesis) implicating at least in part histone demethylase KDM1A resulting in epigenomic repression, and SLC10A1/NTCP (involved in hepatic uptake of conjugated BAs). FXR activates transcription of SLC27A5/BACS and BAAT (involved in BA conjugation), ABCB11/BSEP (involved in bile salt export) by directly recruiting histone methyltransferase CARM1, and ABCC2/MRP2 (involved in secretion of conjugated BAs) and ABCB4 (involved in secretion of phosphatidylcholine in the small intestine). (From Uniprot)
仅用于科研。不用于诊断过程。未经明确授权不得转售。
生物信息学
蛋白别名: Bile acid receptor; farnesoid X nuclear receptor; Farnesoid X-activated receptor; Farnesol receptor HRR-1; MGC163445; nuclear receptor; Nuclear receptor subfamily 1 group H member 4; putative new variant; Retinoid X receptor-interacting protein 14; RXR-interacting protein 14; unnamed protein product
基因别名: BAR; FXR; HRR-1; HRR1; NR1H4; PFIC5; RIP14
UniProt ID: (Human) Q96RI1
Entrez Gene ID: (Human) 9971